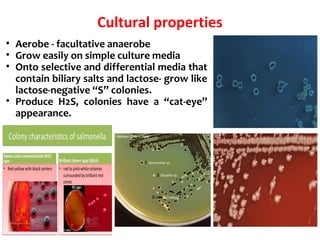
Cultural properties
• Aerobe - facultative anaerobe
• Grow easily on simple culture media
• Onto selective and differential media that
contain biliary salts and lactose- grow like
lactose-negative “S” colonies.
• Produce H2S, colonies have a “cat-eye”
appearance.

Salmonella is a genus of bacteria that can cause illnesses like typhoid fever and food poisoning in humans. There are over 2,500 serotypes of Salmonella, with the most common in the US being Salmonella enterica. Salmonella is transmitted through contaminated food or water, or direct contact with infected animals. In humans, it can cause either an intestinal infection or a more invasive typhoid fever. Salmonella has mechanisms like its Vi capsule and toxins that allow it to invade tissues and survive within host cells. Transmission occurs through the fecal-oral route in animals and humans.